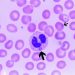
Гранулоцитарный эрлихиоз человека 2 Гранулоцитарный эрлихиоз человека

Европейское агентство по лекарственным средствам (EMA) начало обзор Лемтрада (алемтузумаб) после сообщений о побочных эффектах, влияющих на сердце, кровеносные сосуды, печень и иммунную систему.Эти побочные эффекты редки, но потенциально серьезны.
В качестве временной меры во время проведения обзора ЕМА рекомендовала начинать Лемтраду только у людей с рецидивирующим ремиттирующим РС, который по-прежнему очень активен, несмотря на то, что принимает по меньшей мере два препарата, модифицирующих заболевание (МДД), или там, где другие МДД не могут. быть взятым
Если вы уже начали Лемтраду и хотите получить дальнейшие вливания, вам следует продолжить лечение. Любой, кто проходил курс лечения Лемтрадой, должен продолжать ежемесячно сдавать анализы крови и мочи в течение четырех лет после последнего курса лечения.
Если у вас есть проблемы, вы должны поговорить с вашим неврологом или медсестрой РС.